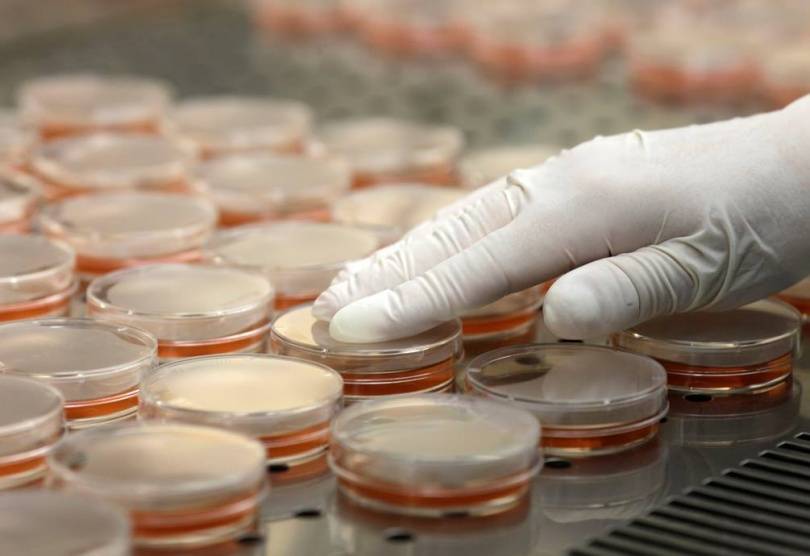

Профилактика заразных болезней крупного рогатого скота (туберкулез, бруцеллез, ящур и др.)
Профилактика сводится к систематической дезинфекции коровников (два раза в год: весной, перед началом пастьбы и осенью перед переводом коров на зимнее содержание), применение дезинфекционных ковриков у всех входов. Кормление должно быть калорийным. В коровниках не должно быть сквозняков, сырости, плохой вентиляции и т.д.
У коров необходимо систематически брать кровь для исследования на туберкулез, бруцеллез, делать прививки от ящура, сибирской язвы, лептоспироза и других болезней.
Из вышесказанного следует, что предупреждение заболеваний крупного рогатого скота всецело зависит от правильности организации всех технологических процессов и норм животноводства, а проведение лечебных мероприятий без соответствующей квалификации может быть опасным как для животного так и для человека (в частности заразные болезни).
Основные внешние признаки заболевания скота.
- Животное становится угнетенным (постоянно находится в положении лежа, иногда и наоборот, постоянно стоит с опущенной головой, наблюдается потускнение, западание глаз).
- Носовое зеркало становился сухим и горячим (в здоровом состоянии у коров оно влажное и холодное).
- Отсутствие аппетита.
- Отсутствие жвачки (становится вялой, редкой или отсутствует).
- У коров понижается молочная продуктивность.
- Повышенная или пониженная температура (нормальной считаются 37,5—39,5 °С) меняется в большую или меньшую сторону в зависимости от типа заболевания (при простуде температура повышается, при отравлении понижается).
- Учащенное дыхание (проявляется при воспалении легких, лихорадке). Нормальное дыхание должно находиться в пределах от 10-30 вдохов в минуту.
Перечень ООИ
Всемирной Организацией Здравоохранения был составлен целый список из более ста болезней, способных быстро и массово распространяться среди населения. Изначально, по данным на 1969 год, в этот список входило всего 3 заболевания:
- чума;
- холера;
- сибирская язва.
Однако позднее список был значительно расширен и все патологии, которые в него вошли, условно были разделены на 2 группы:
1. Заболевания, которые носят необычный характер и могут повлиять на здоровье населения. К ним относят:
- оспу;
- грипп человека;
- полиомиелит;
- тяжелый острый респираторный синдром.
2. Заболевания, любое проявление которых оценивается как угроза, поскольку эти инфекции способны оказывать серьезное влияние на здоровье населения и быстро распространиться в международных масштабах. Сюда же относят заболевания, которые представляют региональную или национальную проблему. К ним относят:
- холеру;
- легочную форму чумы;
- желтую лихорадку;
- геморрагические лихорадки (Ласса, Марбург, Эбола, лихорадка Западного Нила);
- лихорадку денге;
- лихорадку Рифт-Валли;
- менингококковую инфекцию.
В России к этим болезням добавлены еще две инфекции — сибирская язва и туляремия.
Все эти патологии характеризуются тяжелым протеканием, высоким риском смертности и, как правило, составляют базу для биологического оружия массового поражения.
Новости по теме
—
ФГБУ «ВНИИЗЖ» приняло участие в работе совещания по вопросам эпизоотической ситуации в рыбоводных хозяйствах и водных объектах рыбохозяйственного значения РФ
/ 12.08.2021
—
Эпизоотическая ситуация по особо опасным болезням животных в мире с 3 по 9 апреля 2021 года
/ 09.04.2021
—
Эпизоотическая ситуация по особо опасным болезням животных в мире с 20 по 26 марта 2021 года
/ 29.03.2021
—
Эпизоотическая ситуация по особо опасным болезням животных в мире с 1 по 7 августа 2020 года
/ 10.08.2020
—
Эпизоотическая ситуация по особо опасным болезням животных в мире с 1 по 31 июля 2020 года
/ 04.08.2020
—
Эпизоотическая ситуация по особо опасным болезням животных в мире с 25 по 31 июля 2020 года
/ 03.08.2020
—
Эпизоотическая ситуация по особо опасным болезням животных в мире с 30 ноября по 31 декабря 2019 года
/ 10.01.2020
—
Эпизоотическая ситуация по особо опасным болезням животных в мире в 2019 году
/ 09.01.2020
—
Эпизоотическая ситуация по особо опасным болезням животных в мире с 14 по 20 сентября 2019 года
/ 23.09.2019
Виды протекания болезни
Различают следующие варианты протекания воспалительных процессов при сибирской язве:
- Молниеносный
- Манифестный.
- Острый.
- Подострый.
- Хронический.
- Абортивный.
Молниеносный
При этой форме сибирской язвы наблюдают внезапную гибель мелких жвачных. Симптомы заболевания заключаются в возникновении мускульной дрожи, судорог, выделениями изо рта и носа кровянистого экссудата, гибелью за несколько минут. Единичные случаи регистрируют среди лошадей и крупного рогатого скота. Животные возбуждаются, затем такое состояние сменяется угнетением, дыхание становится прерывистым и частым, слизистые приобретают синюшную окраску, развивается гипертермия. Кровянистые истечения происходят из носа, ректального отверстия и рта. Наблюдают нервные явления. Летальный исход происходит в течение нескольких часов.

Смертельный урожай
Манифестный
Сибирская язва у коров и лошадей проистекает, преимущественно, в острой форме и проявляется следующими симптомами:
- Прекращается жвачка и лактация.
- Регистрируется гипертермия — 42 °С.
- Возникает вздутие рубца у КРС.
- Лошади страдают коликами.
- Нарушается ритм дыхания.
- Возникает запор или геморрагический понос.
- Конъюнктива синюшная, с кровоизлияниями в форме точек.
- На шее, груди, животе возникают отеки.
- Во рту и на языке появляются кровянистые инфильтраты.
Заболевание продолжается 2–3 суток и заканчивается гибелью. Предвестниками летального исхода становятся геморрагические истечения из носа и рта.
Подострый
Этот вариант характеризуется теми же признаками, только не такими яркими и развивающимися с меньшей скоростью. Устанавливается временное улучшение состояния, которое быстро сменяется ухудшением. Летальный исход наступает через 6–8 дней после появления клинических симптомов.
Хронический
Протекает со стертыми признаками, главным из которых является нарастающее истощение. Болезнь продолжается 2–3 месяца. Животное выбраковывают, а после убоя обнаруживают в подчелюстной области мускулы, пропитанные геморрагически-студенистым содержимым. Одновременно регистрируют воспаление региональных лимфоузлов.
Абортивный
Самый благоприятный вариант развития сибирской язвы. Проявляется умеренной гипертермией и некоторой вялостью. Животное угнетено, аппетит утрачен, может прекратиться жвачка. Удой резко снижается, корова истощена. Патологическое состояние длится две недели, заканчивается выздоровлением.
Возбудитель сибирской язвы
Возбудитель сибирской язвы — Bacillus anthracis — крупная неподвижная грамположительная спорообразующая аэробная палочка. В организме восприимчивых животных и человека образует капсулу, что характерно для вирулентных штаммов.
Споры образуются при неблагоприятных для жизнедеятельности вегетативной формы условиях — вне организма. В невскрытых трупах споры не образуются.

Спорообразование обеспечивает сохранение В. athracis как вида. Бациллы антракса обладают сложной антигенной структурой (выделены оболочечный, соматический и капсульный антигены).
В организме они продуцируют специфический экзотоксин, включающий иммуногенный (протективный) антиген, воспалительный и летальный факторы.
Вегетативные формы микроба малоустойчивы.
В мягких тканях невскрытого трупа они разрушаются под действием протеолитических ферментов через 7 сут, свежее молоко обладает бактериостатическими свойствами в течение 24 ч.
При 60°С погибают через 15 мин, при 100°С — мгновенно, под действием прямых лучей солнца — через несколько часов, быстро гибнут при воздействии общепринятыми дезинфицирующими средствами.
При -10°С вегетативные клетки выживают 24 дня, в замороженном мясе при — 15°С до 15 дней.
Споры возбудителя сибирской язвы чрезвычайно устойчивы — не погибают в разлагающемся трупном материале, годами сохраняются в воде, десятками лет — в почве.
Сухой жар при 120…140°С убивает их через 2…4 ч, а автоклавирование при 120 °С — через 5… 10 мин, кипячение — через 15… 30 мин. По устойчивости к химическим дезинфицирующим средствам споры возбудителя сибирской язвы относятся к особо устойчивым (4-я группа). Для дезинфекции применяют растворы хлорной извести, нейтрального гипохлорита кальция или препарата ДП-2 с содержанием активного хлора 8 %; 10%-ный горячий гидроксид натрия, 10%-ный одно-хлористый йод, 37%-ный формальдегид в форме аэрозоля, 20%-ный раствор пероксида водорода с добавлением 5%- ной уксусной кислоты в форме аэрозоля, 7%-ный раствор пероксида водорода, 3%-ный раствор йодеза, бромистый метил, ОКЭБМ.
Профилактика
Профилактика ООИ проводится на самом высоком уровне, чтобы предотвратить распространение заболеваний по территории государства. В комплекс первичных профилактических мероприятий входит:
- временная изоляция зараженного с дальнейшей госпитализацией;
- постановка диагноза, созыв консилиума;
- сбор анамнеза;
- оказание больному первой помощи;
- забор материала для лабораторного исследования;
- выявление контактных лиц, их регистрация;
- временная изоляция контактных лиц до момента исключения их заражения;
- проведение текущей и заключительной дезинфекции.
В зависимости от типа инфекции, профилактические мероприятия могут различаться:
- Чума. В природных очагах распространения проводятся наблюдения за численностью грызунов, их обследование и дератизация. В прилегающих районах проводится вакцинация населения сухой живой вакциной подкожно или накожно.
- Холера. Профилактика включает в себя также работу с очагами распространения инфекции. Проводится выявление больных, их изоляция, а также изоляция всех лиц, контактирующих с зараженным. Осуществляется госпитализация всех подозрительных больных с кишечными инфекциями, проводится дезинфекция. К тому же требуется контроль на данной территории за качеством воды и продуктов питания. Если существует реальная угроза, вводится карантин. При угрозе распространения проводится иммунизация населения.
- Сибирская язва. Осуществляется выявление больных животных с назначением карантина, дезинфекция меховой одежды при подозрении на заражение, проведение иммунизации по эпидемическим показателям.
- Оспа. Методы профилактики заключаются в вакцинации всех детей, начиная с 2-х лет, с последующей ревакцинацией. Эта мера практически исключает возникновение оспы.
- Желтая лихорадка. Также осуществляется вакцинация населения. Детям показано введение вакцины с 9-месячного возраста.
Итак, особо опасные инфекции — это смертельные инфекции, которые обладают высокой степенью заразности
За кратчайшие сроки они способны поразить большую часть населению, поэтому крайне важно соблюдать все меры предосторожности в работе с зараженными животными и птицами, а также своевременно проводить вакцинацию
Классификация особо опасных инфекций
Все ООИ классифицируют на три типа:
- Конвенционные заболевания. На такие инфекции распространяются международные санитарные правила. Это:
- бактериальные патологии (чума и холера);
- вирусные заболевания (оспа обезьян, геморрагические вирусные лихорадки).
- Инфекции, которые требуют международного надзора, но не подлежат проведению совместных мероприятий:
- бактериальные (сыпной и возвратный тифы, ботулизм, столбняк);
- вирусные (ВИЧ, полиомиелит, грипп, бешенство, ящур);
- протозойные (малярия).
- Не подлежат надзору ВОЗ, находятся под регионарным контролем:
- сибирская язва;
- туляремия;
- бруцеллез.
Зоны риска и меры предосторожности
Фото Reuters
Инкубационный период сибирской язвы – несколько дней
Травоядные животные
В период повышенной опасности и не только необходимо быть очень осторожными при контакте с крупным и мелким рогатым скотом, лошадьми, верблюдами и свиньями и не позволять играть с этими животными детям.
Мухи, слепни
Защищайте окна и входные двери сетками. Немедленно уничтожайте данных насекомых при их попадании в жилые помещения и кухни, особенно в домах за городом, в непосредственной близости к местам содержания скота.
Заражённые корма для животных
Не покупайте корма для животных у непроверенных производителей, остерегайтесь покупки скошенной травы и сена у случайных продавцов, эта трава могла быть скошена в неблагополучных зонах.
Трупы заражённых животных
Никогда не посещайте мест захоронения заболевших животных, старайтесь избегать любых маршрутов, пролегающих через эти места.
Почва, в которой был захоронен труп павшего животного
Заражённая почва сохраняет инфекционную активность десятилетиями. Никогда не покупайте участки и не селитесь вблизи таких мест, даже если исследования поверхности почвы не выявили опасности. Основные скопления спор сибирской язвы в скотомогильниках находятся глубоко под землей, и любые строительные или земляные работы, а также ливневые и паводковые воды в любой момент легко могут вынести на поверхность смертоносную инфекцию, способную заразить животных и людей.
Заражённое животное сырье
Следует проявлять большую осторожность при покупке шкур, любых меховых и кожаных изделий мелкого кустарного производства. Не покупайте такие товары на стихийных рынках и трассах, у частных продавцов спрашивайте лицензию
Мясо заражённых животных
Любые мясные изделия покупайте только в специальных павильонах, с соблюдением всех санитарных норм и мероприятий. Никогда не приобретайте сырого мяса и мясных изделий у сомнительных продавцов, стихийно торгующих мясом на рынках, во дворах частных домов или прямо из открытых багажников автомобилей на трассах.
Патологоанатомические изменения
Если подозревается сибирская язва, нельзя вскрывать тела павших животных. Ограничиваются осмотром трупов. Они вздуты, ускоренно разлагаются, не окоченевают, из естественных проходов истекает не свернувшаяся темноокрашенная кровь. На слизистых мембранах находят микрогеморрагии. При молниеносной разновидности сибирской язвы обнаружить даже эти признаки не удается. Подозрение вызывают случаи внезапной гибели жвачных. У свиней трудно диагностировать данное заболевание по клинике. При вскрытии или послеубойной экспертизе обнаруживают геморрагическое воспаление лимфатических узелков около шеи, а также глотки.

Ускоренное разложение трупов
Заболевания, вызванные нарушением кормления.
Результатом неправильного кормления, как правило, являются заболевания желудочно-кишечного тракта.
1. Закупорка пищевода происходит в результате застревания неправильно измельченных корнеплодов (необходимо измельчать корнеплоды таким образом, чтобы животное не могло его сразу проглотить, а вынуждала к пережевыванию). При закупорке пищевода корова сильно возбуждена, вытягивает голову, изо рта выделяется пена, при прощупывании шеи наблюдаются утолщения, в результате прекращается жвачка, наблюдается вздутие живота (левого бока). Не рекомендуется самостоятельно проводить лечение животного, при проявлении подобных признаков необходимо немедленно обратится к ветеринарному врачу. В качестве экстренной помощи, животному можно влить 100-200 г растительного масла.
2. Тимпания. Причиной заболевания является переполнение рубца газами. В результате рубец сдавливает легкие и если не принять меры животное может погибнуть от удушья. Тимпания вызывается в результате поедания некачественного корма (заплесневелого или замерзшего и т.д.), большого количества молодой травы (в особенности, бобовых культур), поедания люцерны, клевера, эспарцета после дождя или во время росы, обильное поение после большого количества зеленого корма.
Профилактикой от заболевания тимпанией у крупного рогатого скота заключается в недопущении попадания некачественного корма в рацион, выпас на сочных травах допускается проводить только после схода росы. Запрещается пасти на молодой люцерне и клевере.
3. Антония. Болезнь воздействует на сокращение преджелудков (до полного прекращения). Первичными признаками являются отказ животного от сочных кормов, от концентрированных кормов или полное отсутствие аппетита. Жвачка вялая или отсутствует. Рубец вздутый, корова с трудом передвигается и практически не встает.
При проявлении признаков болезни необходимо перевести животное на грубое кормление с добавлением замоченных отрубей (в качестве слабительного), применять слабительные препараты и средства, усиливающие работу преджелудков и сокращающие брожение (настойка белой чемерицы).
Профилактикой заболевания является недопущение некачественного корма в рационе и перекармливания.
Симптомы и течение заболевания

Фото с сайта redkie-bolezni.com
Кожная форма сибирской язвы
Кожная форма
Кожная форма сибирской язвы встречается чаще всего – в более чем 95% случаев. Если заражение произошло через кожу, то в месте проникновения бактерии сначала ощущается легкое жжение, а затем на коже появляется пятно диаметром 1-3 мм, похожее на укус насекомого. Через несколько часов пятно превращается в узелок медно-красного цвета, зуд и ощущение жжения усиливаются. Через 12-24 часа узелок превращается в пузырь диаметром 2-3 мм, заполненный жидкостью с примесью крови. При расчёсывании, а иногда и самопроизвольно пузырёк лопается, и на его месте образуется язва с тёмно-коричневым дном, приподнятыми краями и гнойным содержимым. Через сутки язва достигает 8-15 мм в диаметре, центральная часть язвы мертвеет и превращается в чёрный струп, вокруг которого нарастает воспалительный валик красного цвета. Обычно язва бывает одна, но иногда количество доходит до 10-20 язв и более. Внешне это напоминает уголёк в ореоле красного пламени, что и послужило поводом для названия бактерии сибирской язвы Bacillus anthracis (аntrax – уголь). Без специального лечения кожная форма сибирской язвы вызывает летальный исход в 20% случаев, но при своевременном обращении к врачу и приеме антибиотиков уровень смертности всё же невысокий.
Кишечная форма
Отличается тяжёлым течением и неблагоприятным исходом в большинстве случаев. При попадании сибирской язвы через желудочно-кишечный тракт в течение первых 1,5 суток наблюдается головная боль, головокружение, боли и жжение в горле, озноб, высокая температура, лихорадка. Во второй фазе присоединяются сильные режущие боли в животе, тошнота, кровавая рвота, жидкий стул с кровью. В третью фазу нарушается сердечная деятельность, больные испытывают тревогу, страх, лица больных становятся розово-синюшного цвета и багровеют. Летальный исход в случае кишечной формы составляет около 50%.
Легочная форма
Если инфекция сибирской язвы проникла через дыхательные пути, распознать её гораздо сложнее, потому что начальные симптомы совершенно неспецифичны: слабость, плохое самочувствие, высокая температура, кашель и боли в груди. Длительность этой фазы составляет от нескольких часов до 2 дней. Затем интоксикация нарастает, отходит кровавая мокрота, температура тела повышается до 39-41 °С, появляются сильные затруднения с дыханием, и может произойти шок. После этого смерть наступает незамедлительно. Летальный исход при легочной форме сибирской язвы превышает 90-95%, даже при соответствующем лечении.

Формы заболевания
Патология протекает у животных в двух разновидностях — септической и карбункулезной. Гнойно-некротическое образование захватывает несколько волосяных луковиц и окружающие текстуры. После вскрытия нагноения формируются изъязвления. Различают первичные карбункулы, возникающие в месте проникновения сибиреязвенной бациллы в дефект кожи, и секундарные, когда развивается сепсис и микробы распространяются по туловищу.
На голове, груди, по всей поверхности тела животного формируются плотные припухлости, на ощупь горячие, при пальпации болезненные. Постепенно болезненность прекращается, в центре образования появляется изъязвление черного цвета, окружающие ткани размягчаются. Воспаленный участок перестает болеть.
Септическая разновидность сибирской язвы характеризуется размножением возбудителя внутри кровяного русла и в паренхиматозных органах. Условно выделяют следующие формы:
- Респираторная.
- Кишечная.
- Ангинозная.
Ангинозная
При этой форме протекание сибирской язвы принимает перманентный характер. Симтомы ангины наблюдают у свиней. Возникает умеренная гипертермия. Животному трудно глотать, оно хрипит, кашляет, наблюдают синюшность видимых слизистых. Сильный отек глотки способен стать причиной смерти от удушья. Предположение о сибирской язве возникает на убойном пункте при ветеринарно-санитарном осмотре туш.

Защитная одежда ликвидаторов сибирской язвы овец
Захоронение погибших
Трупы людей, умерших от сибирской язвы, не подвергаются вскрытию. Только в случае крайней необходимости вскрытие проводит врач со строжайшей последующей дезинфекцией помещения и всех предметов, включая халаты, перчатки, обувь и т.д. Захоронения умерших от сибирской язвы разрешены на обычном кладбище, но всегда принимаются особые меры. В случаях, если труп не вскрывали, его плотно заворачивают в полиэтиленовую плёнку и только потом укладывают в гроб. При захоронении трупа, подвергшегося вскрытию, принимаются дополнительные меры – например, под полиэтиленовую плёнку на дно гроба насыпают слой сухой хлорной извести.
Сибирская язва – клинические проявления
Сибирская язва (карбункул злокачественный, антракс) – быстро протекающая заразная болезнь всех видов животных, включая пушных зверей и человека, с инкубационным периодом обычно около 3—4 дней.
Антракс, от др.-греч. ἄνθραξ «уголь, карбункул»: такое название было дано по характерному угольно-чёрному цвету сибиреязвенного струпа при кожной форме болезни.
Проявляется сибирская язва, как правило, в виде тяжёлого лихорадочного состояния организма, протекает протекает остро и подостро (септическая форма), резкого повышения температуры тела, снижения продуктивности, образования плотных опухолей (карбункулов) на коже, в кишечнике, легких и миндалинах, отказа от корма, кровавой диареи и рвоты, тимпании (метеоризм). Такие проявления особо характерны для крупного и мелкого рогатого скота, лошадей. Ангинозная форма встречается только у свиней и протекает бессимптомно. Изменения можно обнаружить только при ветеринарно-санитарной экспертизе туш по характерному катарально-геморрагическому воспалению лимфатических узлов.
Стремительное развитие инфекционного процесса сибирской язвы, заканчивающегося гибелью животных в течение, как правило, первых 2—3 суток.
Возбудителем сибирской язвы является микроб – бацилла антрацис (Bacillus anthracis).

Возбудитель сибирской язвы это палочковидный микроб (представляет собой довольно крупную палочку длиной 6-10 мкм и шириной 1-2 мкм.), особо устойчив к действию дезинфицирующих средств, например при кипячении он гибнет через 45-60 мин, 1%-ный раствор формальдегида или 10%-ный раствор едкого натра убивает его только через 2 ч. Попадая в почву, обычно через заражённые испражнения и мочу больных животных, микроб образует споры, сохраняющиеся в ней годами.
Споры попадают в кожу через микротравмы. При алиментарном инфицировании (употребление зараженных продуктов) возникает кишечная форма. Передача возбудителя может осуществляться аэрогенным путем (вдыхание инфицированной пыли, костной муки). В этих случаях возникают легочные и генерализованные формы сибирской язвы. В странах Африки допускается возможность передачи инфекции посредством укусов кровососущих насекомых. Заражения человека от человека обычно не наблюдается. Сибирская язва широко распространена во многих странах Азии, Африки и Южной Америки. В США и странах Европы наблюдаются единичные случаи заболеваний сибирской язвой.
Животные заражаются чаще на пастбище или через корма, в которые попали споры сибиреязвенного микроба из почвы. Человек может заразиться при разделке туш или вскрытии трупов животных, больных сибирской язвой.
Сибирская язва может протекать молниеносно, остро и хронически.
При молниеносном течении больной мелкий рогатый скот возбужден, температура тела повышается до 41-42 °С, слизистые оболочки глаз становятся синюшными. Животное внезапно падает и в судорогах погибает. При остром течении наблюдается повышение температуры тела до 42 °С, дрожь, синюшность слизистых оболочек глаз и кровоизлияние, а также вздутие рубца (тимпания).
Продолжительность болезни до 2-3 суток. Хроническое течение проявляется похуданием, отеками под нижней челюстью и опуханием подчелюстных и заглоточных лимфатических узлов. Нередко сибирская язва проявляется в так называемой карбункулезной форме, при которой на месте проникновении возбудителя и других участках тела появляется твердый, хорошо очерчиваемый болезненный отек кожи и подкожной клетчатки, а в дальнейшем в центре отека образуются язвы.
Труп павшего от сибирской язвы животного вздут, окоченение отсутствует, из анального отверстия, рта и ноздрей выделяется кровянистая жидкость или несвернувшаяся кровь темного цвета. На коже обнаруживаются припухлости.
При подозрении на сибирскую язву нужно срочно вызвать ветеринарного врача. Вскрывать трупы при подозрении на данное заболевание и снимать с них шкуру категорически запрещается.
Лечение сибирской язвы
Лечение осуществляет только ветеринарный врач, применяя противосибиреязвенную сыворотку внутримышечно в дозе 50-100 мл на голову или гамма-глобулин – 20-40 мл, антибиотики, например пенициллин внутримышечно 4-10 тысяч ЕД/кг и другие препараты.
Основой профилактики является ежегодная вакцинация животных против сибирской язвы: взрослый мелкий рогатый скот – дважды в год с интервалом в 6 мес, молодняк – в 3 мес с последующей ревакцинацией через каждые 3 мес. У переболевших животных возникает стойкий и длительный иммунитет.
Диагностика
На первое место ставят эпизоотическую обстановку. Подозревать возникновение сибирской язвы следует в нижеперечисленных ситуациях:
Внезапный падеж:
- На неблагоприятной территории.
- После паводка или земельных работ.
Клинические признаки:
- Лихорадка, интоксикация.
- Синюшность слизистых.
- Точечные кровоизлияния.
- Наличие карбункулов.
- Ангина у свиней.
- Колики у лошадей.
Обследование трупов:
- Нет окоченения.
- Геморрагические выделения из отверстий тела.
- Ускоренное разложение трупов.

Колики при кишечной форме сибирской язвы
Сибирскую язву ликвидируют при помощи масштабных и затратных профилактических мероприятий, для начала которых необходима лабораторная диагностика. Заболевание опасно для человека, отбор проб для анализа совершается опытным ветеринарным врачом при соблюдении правил личной гигиены и недопущения распространения инфекции. После надлежащей упаковки патматериала его экстренно отправляют в лабораторию.
Обнаруживают обсемененность спорами сибирской язвы объектов, кормов и механизмов, руководствуясь специальными Методическими указаниями. Возбудителя идентифицируют способами ИФА, а также ПЦР.
Некоторые симптомы антракса аналогичны признакам пастереллеза, эмкара, пироплазмоза, энтеротоксемии, брадзота, поэтому лабораторные анализы необходимы для выявления возбудителя.
Прижизненная диагностика сибирскрй язвы у свиней заключается во внутрикожной инъекции аллергена Антраксина.







